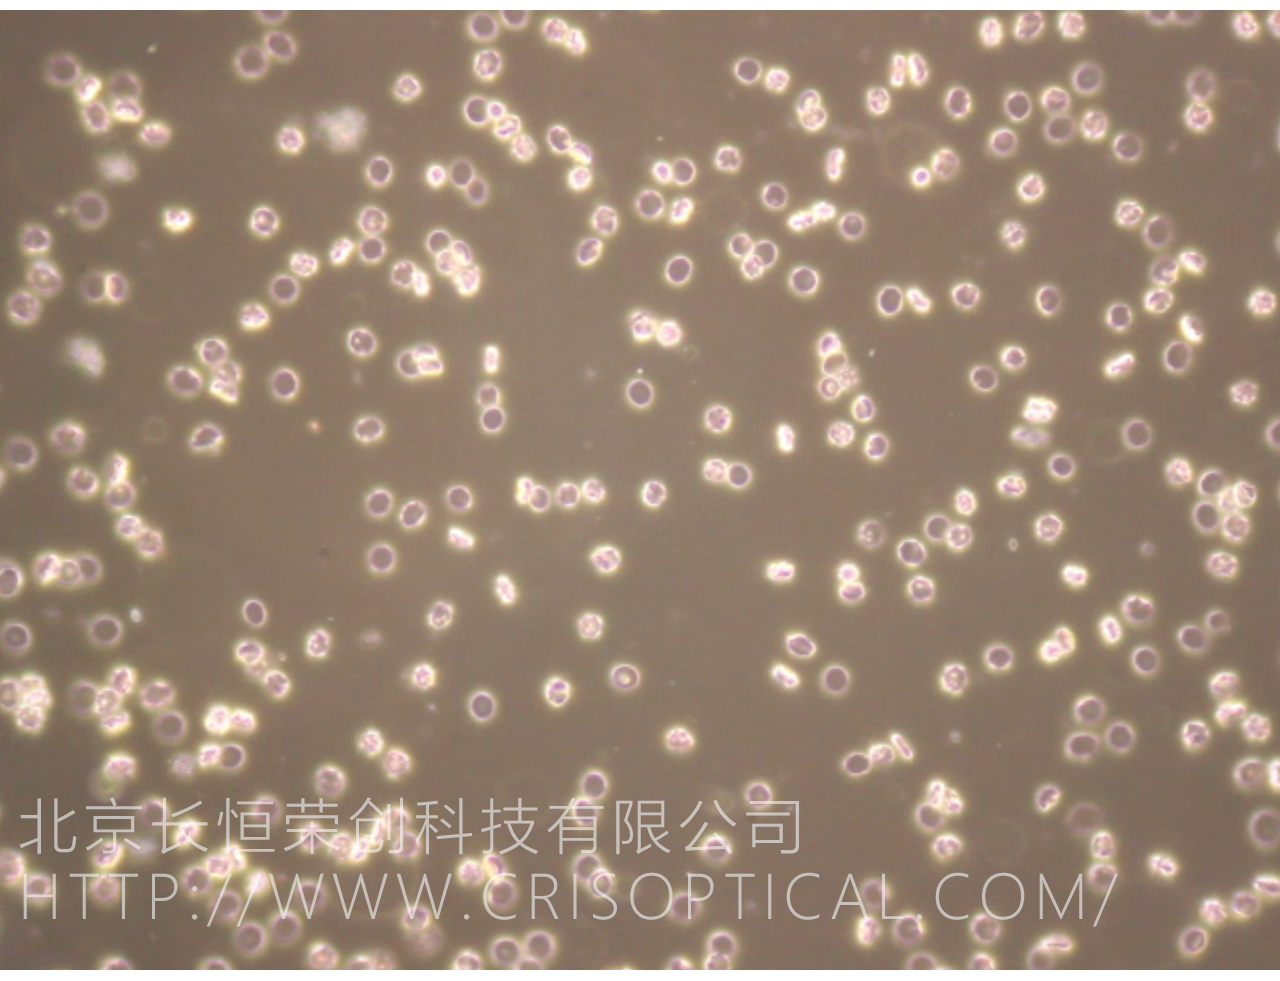

細菌暗場觀察 顯微鏡 觀察 操作 實驗 研究
- 編輯 :
長恒榮創(chuàng)
時間 : 2024-08-07 11:24 瀏覽量 : 211
相關(guān)新聞
- 神經(jīng)細胞 干細胞 貼壁細胞 顯微鏡 觀察 操作 08-07
- 革蘭氏染色 顯微鏡 觀察 操作 實驗 研究 倍數(shù) 08-07
- 病理切片 顯微鏡 觀察 操作 實驗 研究 倍數(shù) 圖片 08-07
- 菌絲 顯微鏡 觀察 操作 實驗 研究 倍數(shù) 圖片 08-07
- 巖石玻片偏光 顯微鏡 觀察 操作 實驗 研究 倍數(shù) 08-07
- 植物細胞顯微鏡 植物細胞熒光顯微鏡 植物細胞觀 08-07
- 微流控?zé)晒怙@微鏡研究與觀察 08-07
- 飛灰觀察顯微鏡 油水飛灰觀察 飛灰顆粒研究 08-07
- 胚胎 體視顯微鏡觀察 實驗研究 配置方法 案例圖 08-07
- 晶狀體體視顯微鏡 眼球觀察顯微鏡 小鼠眼球解刨 08-07